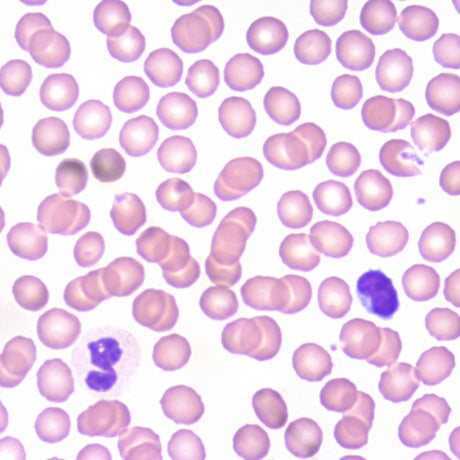
Hämatologie

Anwendungen
Mikroskope nach Anwendung entdeckenZubehörteile
Alle anzeigenWir finden das passende Zubehör
Die Auswahl an Zubehörteilen ist groß und oft sehr individuell. Gerne sind wir Ihnen bei der Wahl des passenden Zubehörs behilflich. Fragen Sie uns!

Sonderlösungen
ASKANIA - Ihr Partner für optische Systemlösungen
Benötigen Sie einen bestimmten Aufbau eines Mikroskops für eine Anwendung in Ihrem Unternehmen?
ASKANIA ist erfahren mit Projekten von Neuentwicklungen für bestimmte Einsatzmöglichkeiten. Sollte der vorhandene Arbeitsplatz zu klein oder die Bedienung aufgrund des Standortes mit einem gewissen Abstand erfolgen, muss das Mikroskop bestimmte Voraussetzungen mit sich bringen.
Neuentwicklung - Entwicklung von neuen Mikroskopen und Systemen
Zusammenstellen - Konfigurieren individueller Optiklösungen
Herstellung - von Bauteilen im eigenen Maschinenpark
Erweiterung - Umbau, Anpassung oder Erweiterung Ihrer Mikroskope